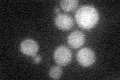
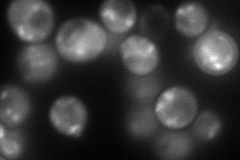
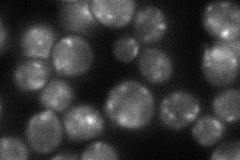
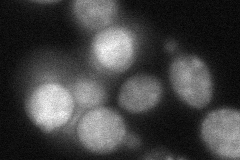

View description
Protein required for Golgi localization of glycosyltransferases; binds the cytosolic domains of Golgi glycosyltransferases; binding to PtdIns4P required for Golgi targeting and function; tetramer formation required for function
Localization:
Intensity:
Fold change:
Significance:
-
C’ GFP library in SD
cytosol19.38 -
N' NOP1pr-GFP in SD
punctate159.125 -
N' TEF2pr-mCherry in SD

cytosol,punctate294.146 -
N' NATIVEpr-GFP in SD
punctate72.0083 -
N' TEF2pr-VC and Cyto-VN in SD
cytosol61.0149 -
C’ GFP library in SD+DTT

cytosol18.640.96No -
C’ GFP library in SD+H2O2

cytosol15.790.81No -
C’ GFP library in Starvation Media

cytosol15.170.78No -
C’ GFP library on the background of Pup2-DaMP

cytosol -
C’ GFP library on the background of CCT mutant

cytosol19.15580.988342No
